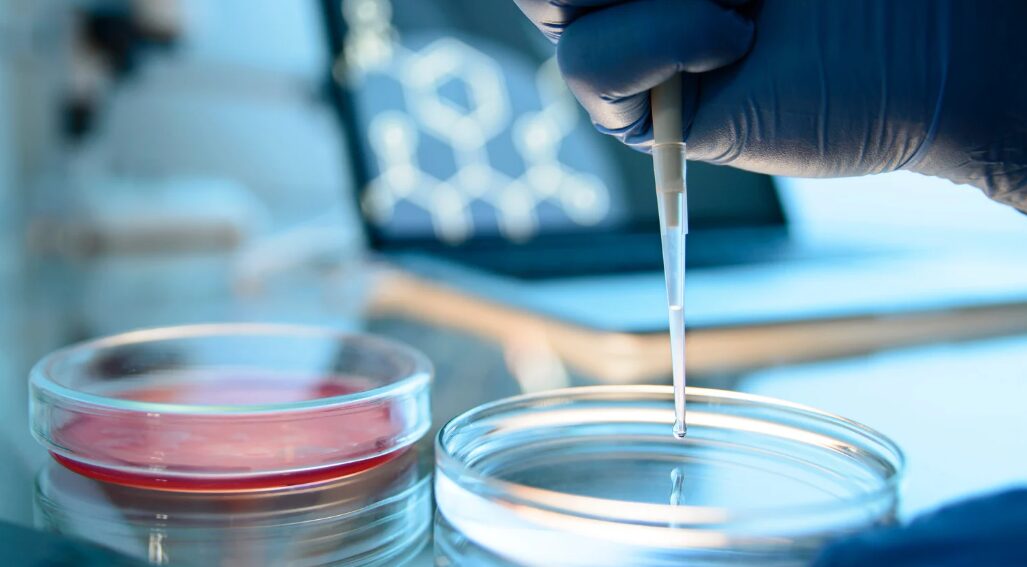

A identificação de microrganismos é intrínseca em áreas como microbiologia clínica, controle de qualidade de alimentos, pesquisa ambiental e biotecnologia. Duas das principais ferramentas usadas para esse fim são as placas de cultura e o PCR – Reação em Cadeia da Polimerase. As placas de cultura são métodos tradicionais que permitem o crescimento e a observação direta dos microrganismos, enquanto o PCR é uma técnica moderna baseada em biologia molecular que detecta o material genético dos microrganismos. Neste texto, vamos comparar essas duas abordagens para entender qual é mais eficaz na identificação microbiana.
Placa de Petri
A placa de Petri, inventada em 1887 pelo bacteriologista alemão Julius Richard Petri, é um recipiente redondo, raso e com tampa, geralmente feito de plástico ou vidro, preenchido com um meio de cultura, que é uma substância nutritiva – normalmente à base de ágar – onde os microrganismos podem crescer. Após a amostra ser colocada na placa, ela é mantida em temperatura adequada para que os microrganismos se desenvolvam, formando colônias visíveis a olho nu. Essas colônias podem ser analisadas para identificar o tipo de microrganismo presente, com base em sua forma, cor, cheiro e crescimento.
A placa de Petri é uma das ferramentas mais clássicas e simples da microbiologia, sendo muito usada em hospitais, escolas, laboratórios e pesquisas científicas.
PCR
Por outro lado, PCR é uma técnica laboratorial usada para amplificar uma pequena quantidade de DNA, ou seja, fazer milhões de cópias de um trecho específico do DNA em poucas horas. Se existe apenas uma amostra minúscula de DNA (como saliva, sangue, ou tecido), o PCR permite multiplicar esse DNA para que ele possa ser analisado com mais facilidade.
Na década de 80, o PCR foi descrito por Kary Mullis, que lhe rendeu um prêmio Nobel em conjunto com Michael Smith. Smith desenvolveu um procedimento conhecido como mutagênese sítio dirigida e aplicou-o ao estudo de proteínas. A partir de suas pesquisas, surgiu uma variação do PCR chamada PCR-RFLP, que ajuda a identificar mudanças no DNA e pode ser usada para detectar, por exemplo, o vírus HPV. O PCR também pode ser feito em tempo real para detectar mutações no DNA, usando uma análise chamada “curva de melting”. Isso acontece quando o DNA amplificado é aquecido e, com isso, seu comportamento pode revelar alterações no material genético.
No começo da técnica de PCR, usava-se uma enzima que só funcionava em temperaturas baixas e era destruída quando o DNA precisava ser aquecido, o que tornava o processo difícil. Depois, Mullis descobriu a Taq polimerase, uma enzima resistente ao calor vinda de uma bactéria que vive em fontes termais. Isso facilitou muito o uso da PCR, tornando-a mais rápida e eficiente.
Comparação entre as duas técnicas
A placa de Petri apresenta menor custo de execução, embora demande mais tempo para o crescimento microbiológico. Essa técnica é eficaz para a detecção de determinadas bactérias. No entanto, existem microrganismos que não crescem em meio à cultura, mas podem ser identificados por PCR. Por exemplo, o PCR é a única das duas técnicas capaz de detectar vírus. Ele apresenta um custo mais elevado, porém oferece resultados mais rápidos e com maior precisão, além de não exigir que a amostra sobreviva.
Dessa forma, os testes devem ser considerados como complementares, de modo a proporcionar um resultado mais confiável. Assim, não se deve apontar qual técnica é superior sem compreender o contexto. Na verdade, é necessário avaliar qual delas se adequa melhor à situação em estudo.
A Protos Biotec Jr. possui um serviço de Análises Laboratorias, que inclui o uso de placas petri para identificação de microorganismos. Interessado (a)? Contate-nos!!
Referências
OLIVEIRA, I. T.; ZUCCHERATTO, K. M. C.; GRANADO, I. Z.; MELLO, P. H.; OLIVEIRA, H. P. M. De onde vêm os nomes das vidrarias de laboratório? Química Nova, v. 41, n. 8, p. 933–942, 2018.
MENÊSES, M. S. L.; TORALLES, M. B. P.; MENDES, C. M. C. Evolução da técnica de PCR: sua contribuição no diagnóstico da infecção por HPV. Revista de Ciências Médicas e Biológicas, v. 18, n. 3, p. 361–366, 20 dez. 2019.
TORTORA, Gerard J.; FUNKE, Berdell R.; CASE, Christine L. Microbiologia. 11. ed. Porto Alegre: Artmed, 2017.
